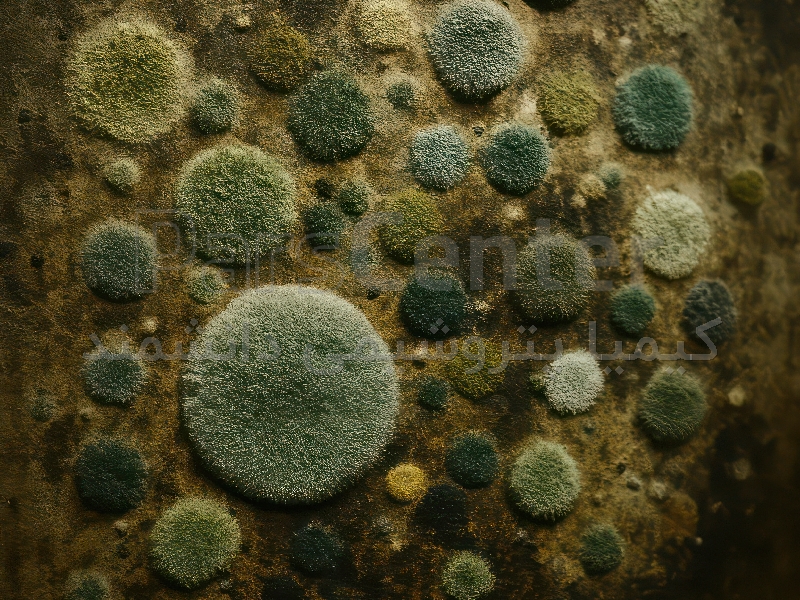

افزودنی ضد قارچ و ضد کپک صنعتی برای کنترل کامل آلودگیها
ضد قارچ صنعتی و افزودنی ضد کپک صنعتی ترکیبی مؤثر برای کنترل آلودگی صنعتی و حفظ بهداشت در محیط های تولید است. این محصول با عملکرد قوی در جلوگیری از رشد قارچ، کپک و باکتریها، به افزایش عمر تجهیزات و کیفیت محصولات نهایی کمک میکند.
مشخصات
- شرکت سازنده :
- کیمیا پتروشیمی دانشمند
- کشور سازنده :
- ایران
توضیحات محصول
فروش ضد قارچ و افزودنی ضد کپک صنعتی یکی از مؤثرترین ترکیبات برای جلوگیری از آلودگیهای میکروبی در خطوط تولید و محیطهای صنعتی است. این مواد با کنترل آلودگی صنعتی، از رشد قارچ، کپک و جلبک جلوگیری کرده و باعث حفظ کیفیت محصولات و ایمنی محیط کار میشوند.
ضد قارچ صنعتی در صنایع غذایی، چرم، دارویی و شیمیایی نقش مهمی در افزایش طول عمر تجهیزات و کاهش هزینههای نگهداری دارد.
کاربرد و ویژگیها:
محافظت از تجهیزات و خطوط تولید در صنایع مختلف
کنترل و پیشگیری از آلودگی قارچی و میکروبی در محیط های صنعتی
افزایش بهرهوری و بهداشت صنعتی
کاهش خطرات زیستمحیطی با مصرف کنترلشده
بهبود کیفیت محصولات نهایی و شرایط کاری
برای دریافت اطلاعات فنی، نمونه محصول یا استعلام قیمت با کارشناسان ما تماس بگیرید.
ورود به سایت
📞 0261817